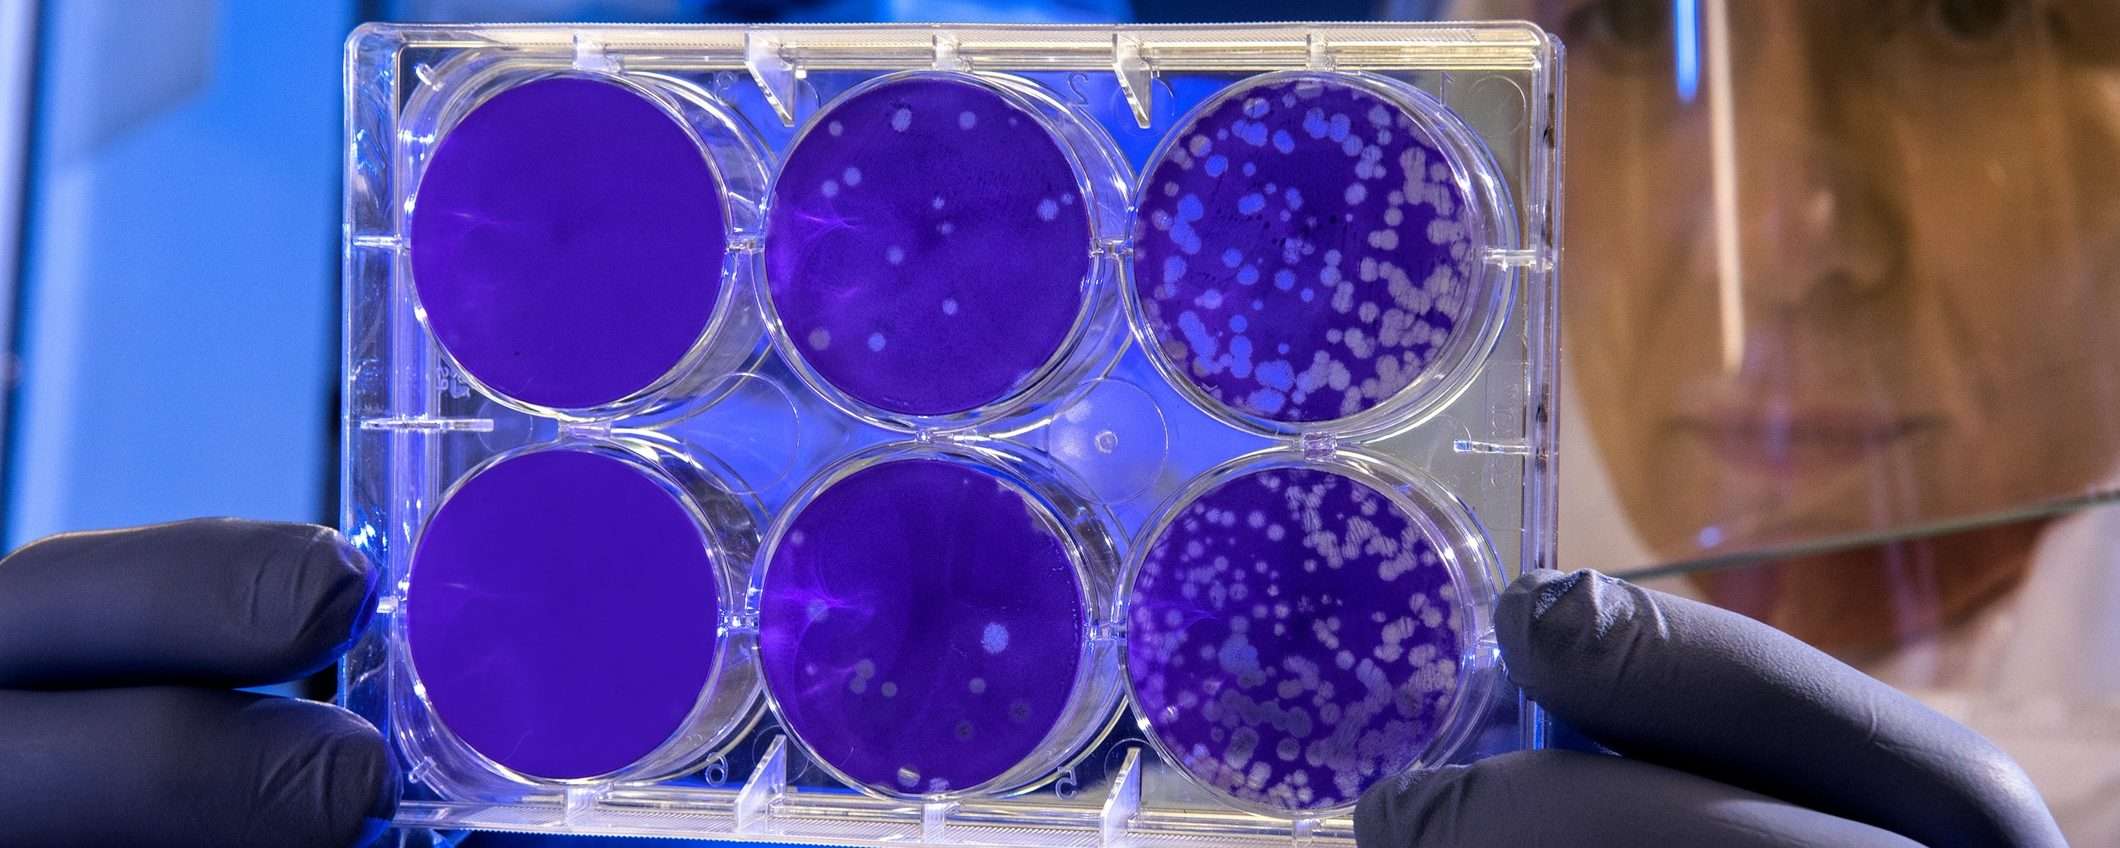

L’intelligenza artificiale sta rivoluzionando anche il settore della medicina. Grazie all’AI un gruppo di scienziati ha conseguito un risultato senza precedenti: la scoperta dei primi nuovi antibiotici degli ultimi 60 anni.
L’impiego dell’intelligenza artificiale, infatti, ha permesso agli esperti di identificare un composto in grado di combattere un batterio resistente ai farmaci, che provoca la morte di migliaia di persone in tutto il mondo ogni anno. Questo importante risultato potrebbe rappresentare una significativa svolta nella battaglia contro l’antibiotico-resistenza.
L’AI aiuta gli scienziati a scoprire nuovi antibiotici in tempi record
Secondo quanto affermato dal professor James Collins, docente di ingegneria medica e scienza presso il Massachusetts Institute of Technology (MIT) e uno degli autori dello studio: “Abbiamo avuto l’intuizione di esaminare ciò che i modelli di intelligenza artificiale avevano imparato per formulare previsioni sulla capacità di determinate molecole di agire come antibiotici efficaci.”
Il loro lavoro ha fornito una struttura efficace in termini di tempo, risorse e comprensione meccanica della struttura chimica, in modi che finora non erano stati sperimentati. I risultati di questa ricerca, realizzati da un team di 21 ricercatori, sono stati pubblicati su Nature.
Il team di ricercatori ha impiegato un modello di deep learning per predire l’attività e la tossicità del nuovo composto identificato.
L’apprendimento profondo coinvolge l’utilizzo di reti neurali artificiali per acquisire e rappresentare automaticamente le caratteristiche dei dati senza richiedere una programmazione esplicita. Questo approccio viene sempre più utilizzato nella scoperta di farmaci per accelerare l’individuazione di potenziali candidati, prevedere le loro proprietà e ottimizzare il processo di sviluppo dei medicinali.
Nuove molecole antibiotiche contro il MRSA
Nel caso specifico dello studio, l’attenzione dei ricercatori si è concentrata sullo Staphylococcus aureus resistente alla meticillina (MRSA). Le infezioni da MRSA possono variare da lievi infezioni cutanee a condizioni più gravi e potenzialmente fatali come la polmonite e le infezioni del flusso sanguigno. Secondo il Centro europeo per la prevenzione e il controllo delle malattie (ECDC), ogni anno nell’Unione europea si verificano quasi 150.000 infezioni da MRSA e quasi 35.000 persone muoiono a causa di infezioni resistenti agli antimicrobici.
Il team di ricercatori del MIT ha addestrato un modello di deep learning notevolmente ampliato utilizzando set di dati più ampi. Per creare i dati di addestramento, sono state valutate circa 39.000 molecole per la loro attività antibiotica contro l’MRSA. I dati risultanti, insieme ai dettagli sulle strutture chimiche delle molecole, sono stati quindi inseriti nel modello.
Per ottimizzare la selezione dei potenziali farmaci, i ricercatori hanno impiegato tre ulteriori modelli di deep learning. Questi modelli sono stati attentamente addestrati per valutare la tossicità dei composti su tre diversi tipi di cellule umane. Unendo queste previsioni di tossicità con l’attività antimicrobica precedentemente determinata, i ricercatori hanno individuato i composti in grado di combattere efficacemente i microbi, minimizzando al contempo i danni al corpo umano.
L’intelligenza artificiale al servizio della medicina
Attraverso l’utilizzo di questa serie di modelli, sono stati esaminati circa 12 milioni di composti disponibili sul mercato. I modelli hanno identificato composti appartenenti a cinque diverse classi, basate su specifiche sottostrutture chimiche all’interno delle molecole, che hanno dimostrato un’attività predittiva contro l’MRSA.
In un secondo momento, i ricercatori hanno selezionato circa 280 di questi composti e li hanno sottoposti a test di laboratorio per valutarne l’efficacia contro l’MRSA. Grazie a questo approccio, sono stati individuati due promettenti candidati antibiotici appartenenti alla stessa classe.
Attraverso una serie di esperimenti condotti su due modelli murini, uno per l’infezione cutanea da MRSA e l’altro per l’infezione sistemica da MRSA, entrambi questi composti hanno dimostrato di ridurre la popolazione di MRSA di 10 volte.